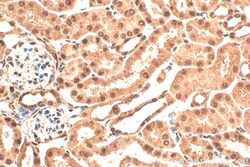
VIRMA/KIAA1429 Rabbit Polyclonal Antibody, Proteintech Unconjugated; 150

missing translation for 'onlineSavingsMsg'
Learn More
Learn More
VIRMA/KIAA1429 Rabbit Polyclonal Antibody, Proteintech
Rabbit Polyclonal Antibody
Brand: Proteintech 30166-1-AP-150UL
This item is not returnable.
View return policy
Description
The VIRMA/KIAA1429 antibody from Proteintech is a rabbit polyclonal antibody generated with recombinant protein of human VIRMA/KIAA1429. This antibody recognizes human, mouse antigen. The VIRMA/KIAA1429 antibody has been validated for the following applications: WB, IHC, IF/ICC, ELISA analysis.Specifications
| VIRMA/KIAA1429 | |
| Polyclonal | |
| Unconjugated | |
| Rabbit | |
| Antigen affinity purification | |
| RUO | |
| 25962 | |
| Store at -20°C. Stable for one year after shipment. | |
| Polyclonal Antibody | |
| IgG |
| Western Blot, Immunohistochemistry, Immunocytochemistry/Immunofluorescence, ELISA | |
| 550 μg/mL | |
| DKFZp434I116; DKFZp781B2117; MGC138493; MGC141940; MSTP054; fSAP121 | |
| Recombinant Protein | |
| 150 μL | |
| Primary | |
| Human, Mouse | |
| 200-210 kDa | |
| Liquid |
Product Content Correction
Your input is important to us. Please complete this form to provide feedback related to the content on this product.
Product Title
Spot an opportunity for improvement?Share a Content Correction